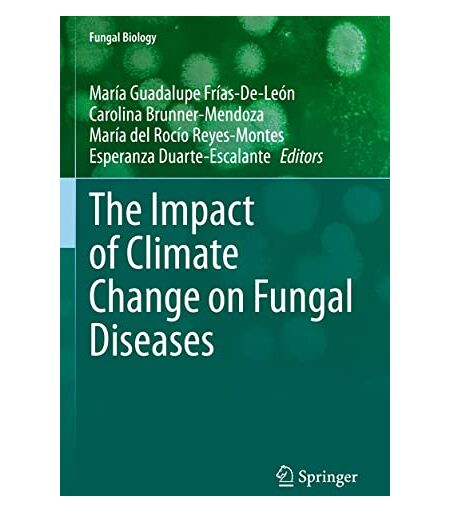

Frías-De-León, María Guadalupe - The Impact of Climate Change on Fungal Diseases (Fungal Biology)
143,64 €
Gratis-Versand
Brand : MOXIC, Binding : Taschenbuch, Edition : 1st ed. 2022, Label : Springer, Publisher : Springer, medium : Taschenbuch, numberOfPages : 320, publicationDate : 2023-03-09, releaseDate : 2023-03-09, publishers : Frías-De-León, María Guadalupe, Carolina Brunner-Mendoza, Reyes-Montes, María del Rocío, Esperanza Duarte-Escalante, ISBN : 3030896668 ...
Ähnliche Produkte könnten Sie interessieren
Verkauft durch | Stückpreis | Lieferung | Gesamtpreis | |
---|---|---|---|---|
MEDIMOPS | 143,64 € | Gratis-Versand | 143,64 € |